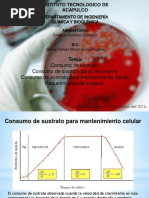

UNIVERSIDAD DE GUAYAQUIL
FACULTAD DE INGENIERÍA QUÍMICA
CARRERA DE INGENIERÍA QUÍMICA
INFORME DE PRÁCTICA
Extracción de ADN de una frutilla
INTEGRANTES: Bedor Medina Grabriela
Carrera Nathaly
Coello Flores Bryan
Ponce Salazar José
PARALELO: IQ- 2C
DOCENTE: Dra. Olga Quevedo Pinos
Asignatura: Biología
Ciclo
2019-2020 CI
� Extracción del ADN de una fresa
Introducción:
Por medio de este experimento realizado se puede observar como el ADN se puede
extraer de una forma sencilla y casera. El ADN de la frutilla fue extraído gracias al
seguimiento adecuado de los pasos y a que se utilizaron materiales prácticos pero
efectivos para la realización de este experimento.
Objetivo General:
Extraer el ADN de la frutilla.
Objetivos Específicos
Aprender a determinar el ADN de la frutilla utilizando materiales sencillos de conseguir.
MARCO TEÓRICO: El ADN es la macromolécula base de la herencia. Es un ácido
nucleico que contiene la información de las características hereditarias de cada ser vivo y
las secuencias para la creación de aminoácidos que generarán las proteínas vitales para el
funcionamiento de los organismos. El ADN o DNA (por sus siglas en inglés) son siglas
para ácido desoxirribonucleico y tiene como función principal el almacenamiento de toda
la información necesaria para la expresión de determinadas características, en segmentos
denominados genes o empaquetada en cromosomas.
Materiales:
Agua
Frutillas
Sal
Jabón Líquido
2 vasos
1 cuchara
Alcohol
Jeringa
Palillo
Cernidero
Bolsa plástica
Mandil
Procedimiento:
1. Colocar el alcohol (10ml) en el congelador de esta manera se logra disminuir su
temperatura.
2. Introducir las frutillas en una bolsa plástica y se procede a aplastarlas o
machacarlas hasta el punto que quede una pasta.
3. Pasamos por el cernidero la pasta obtenida, y lo cernido se lo coloca en un vaso.
4. Posterior a eso, en otro vaso, se colocan 90ml de agua, 8 ml de jabón líquido y
una cucharadita de sal, finalmente mezclamos bien con la cuchara.
5. Añadimos la mezcla cernida en el vaso que contiene el alcohol con el jabón y la
sal y mezclamos.
� 6. Como último paso, se agregan 10 ml de alcohol a la mezcla final, inclinando un
poco el vaso y se lo deja reposar. Al transcurrir unos minutos se puede observar
el cambio y como aparece una “tela transparente” encima de la mezcla, este
vendría a ser el ADN de la frutilla.
Descripción del experimento:
Se escogió a la fresa debido que es la fruta con la que se obtiene más ADN. Son
octoploides, lo que significa que tiene 8 juegos idénticos de cromosomas, y es por esta
razón que es más fácil extraer su ADN.
Función de los componentes:
Jabón líquido: El jabón hace que la célula vacié su contenido molecular en una
disolución tampón en la que se disuelve el ADN en ese momento, el tampón contiene
ADN y todo un surtido de restos moleculares: ARN, carbohidratos, proteínas y otras
sustancias en menor proporción las proteínas asociadas al ADN, de gran longitud, se
habrán fraccionado en cadenas más pequeñas y separadas de el por acción del jabón.
Sal: La sal común (NaCl), con esa concentración, es un medio hipertónico que provoca
el estallido de las células y los núcleos, quedando libre las fibras de cromatina. El jabón
cumple la misión de formar un complejo con las proteínas histonas y separarlas del ADN.
Alcohol: El alcohol etílico sirve para precipitar el ADN.
Anexos: